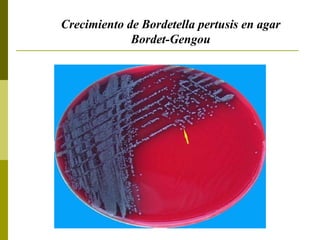
Crecimiento de Bordetella pertusis en agar Bordet-Gengou

El documento presenta una revisión exhaustiva sobre las infecciones respiratorias altas agudas, desglosando los microorganismos involucrados, sus mecanismos de acción y los tipos de infecciones que pueden causar. Se detalla el diagnóstico y tratamiento de afecciones comunes como la rinitis, la faringitis, la amigdalitis, la tos ferina y el síndrome de Lemierre, así como las complicaciones asociadas y la importancia de las defensas locales. Además, se mencionan las medidas de prevención, como la vacunación contra la influenza.